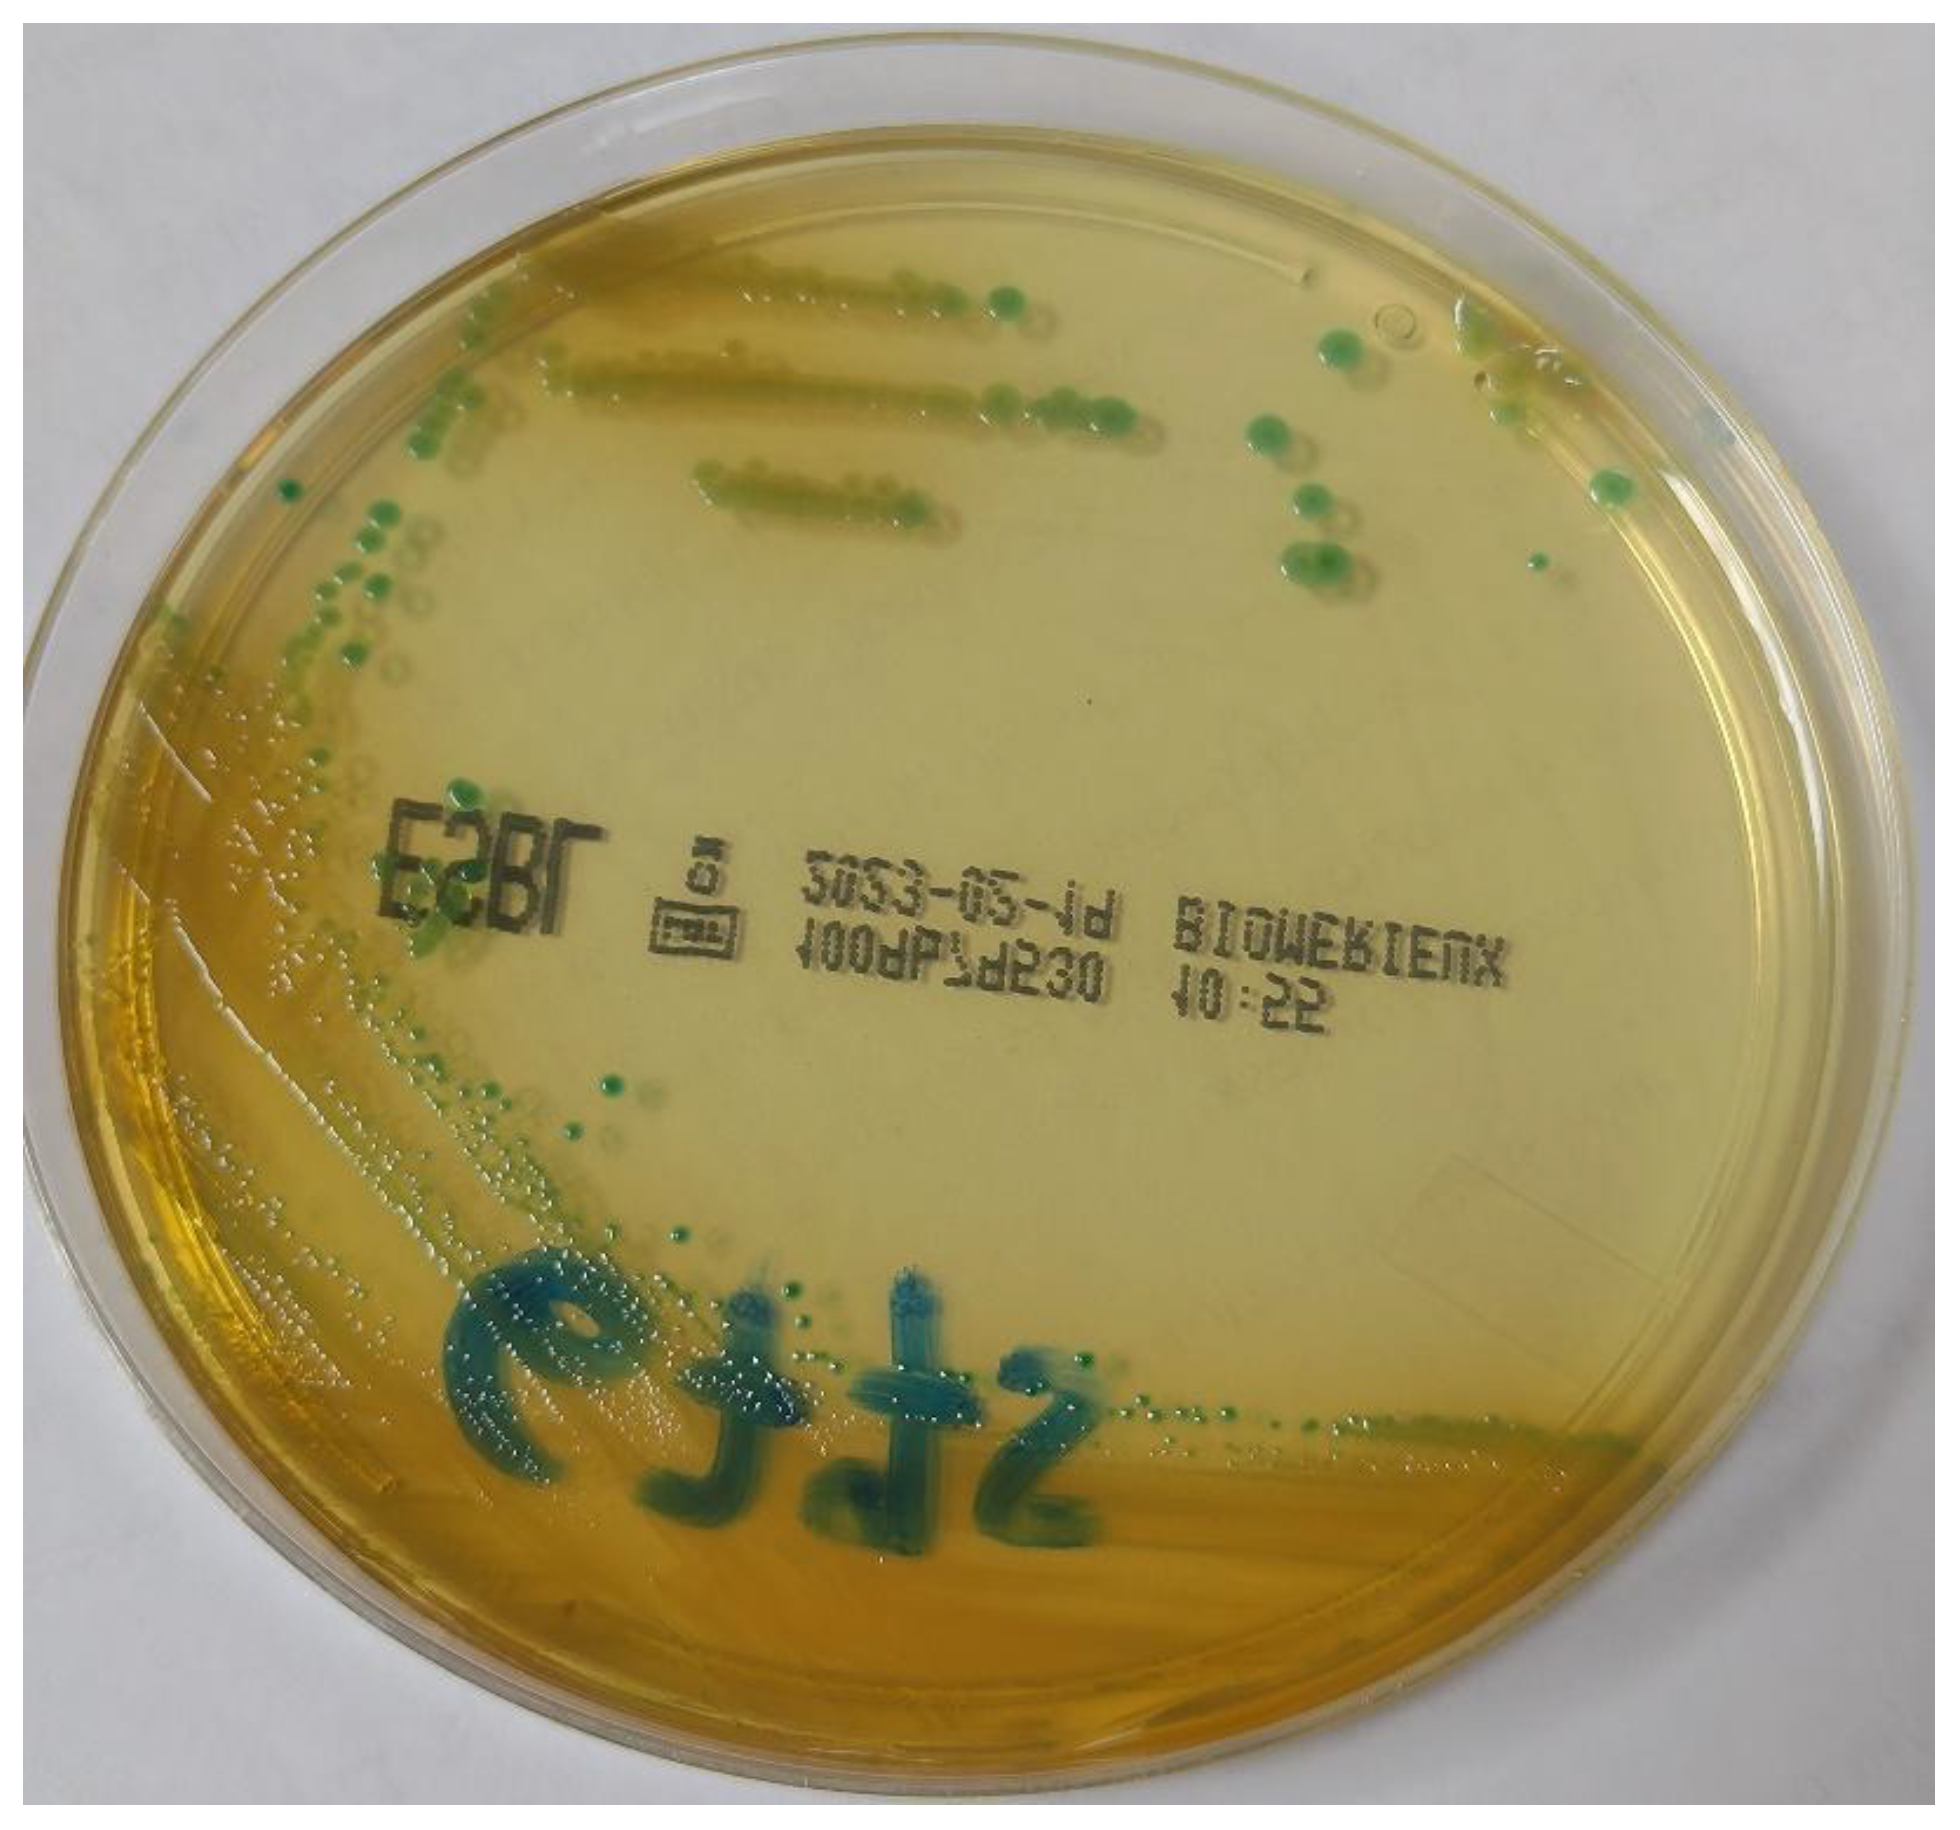
Antibiotics 12 00098 g001 Antibiotics 12 00098 g001

Surveillance in a Neonatal Intensive Care Unit Allowed the Isolation of a Strain of VIM-Producing Pantoea brenneri
Abstract
1. Introduction
2. Case Description
3. Microbiological Investigations
4. Discussion
Author Contributions
Funding
Institutional Review Board Statement
Informed Consent Statement
Data Availability Statement
Acknowledgments
Conflicts of Interest
References
- Cruz, A.T.; Cazacu, A.C.; Allen, C.H. Pantoea agglomerans, a Plant Pathogen Causing Human Disease. J. Clin. Microbiol. 2007, 45, 1989–1992. [Google Scholar] [CrossRef] [PubMed]
- Brady, C.; Cleenwerck, I.; Venter, S.; Engelbeen, K.; De Vos, P.; Coutinho, T.A. Emended description of the genus Pantoea, description of four species from human clinical samples, Pantoea septica sp. nov., Pantoea eucrina sp. nov., Pantoea brenneri sp. nov. and Pantoea conspicua sp. nov., and transfer of Pectobacterium cypripedii (Hori 1911) Brenner et al. 1973 emend. Hauben et al. 1998 to the genus as Pantoea cypripedii comb. nov. Int. J. Syst. Evol. Microbiol. 2010, 60 (Pt 10), 2430–2440. [Google Scholar] [CrossRef] [PubMed]
- Dutkiewicz, J.; Mackiewicz, B.; Kinga Lemieszek, M.; Golec, M.; Milanowski, J. Pantoea agglomerans: A mysterious bacterium of evil and good. Part III. Deleterious effects: Infections of humans, animals and plants. Ann. Agric. Environ. Med. 2016, 23, 197–205. [Google Scholar] [CrossRef] [PubMed]
- Aly, N.Y.A.; Salmeen, H.N.; Lila, R.A.A.; Nagaraja, P.A. Pantoea agglomerans Bloodstream Infection in Preterm Neonates. Med. Princ. Pract. 2008, 17, 500–503. [Google Scholar] [CrossRef] [PubMed]
- Mani, S.; Nair, J. Pantoea Infections in the Neonatal Intensive Care Unit. Cureus 2021, 13, e13103. [Google Scholar] [CrossRef] [PubMed]
- Habsah, H.; Zeehaida, M.; van Rostenberghe, H.; Noraida, R.; Pauzi, W.I.W.; Fatimah, I.; Rosliza, A.R.; Sharimah, N.Y.N.; Maimunah, H. An outbreak of Pantoea spp. in a neonatal intensive care unit secondary to contaminated parenteral nutrition. J. Hosp. Infect. 2005, 61, 213–218. [Google Scholar] [CrossRef]
- Curiao, T.; Morosini, M.I.; Ruiz-Garbajosa, P.; Robustillo, A.; Baquero, F.; Coque, T.M.; Cantón, R. Emergence of blaKPC-3-Tn4401a associated with a pKPN3/4-like plasmid within ST384 and ST388 Klebsiella pneumoniae clones in Spain. J. Antimicrob. Chemother. 2010, 65, 1608–1614. [Google Scholar] [CrossRef]
- Cantón, R.; Akóva, M.; Carmeli, Y.; Giske, C.G.; Glupczynski, Y.; Gniadkowski, M.; Livermore, D.M.; Miriagou, V.; Naas, T.; Rossolini, G.M.; et al. Rapid evolution and spread of carbapenemases among Enterobacteriaceae in Europe. Clin. Microbiol. Infect. 2012, 18, 413–431. [Google Scholar] [CrossRef]
- Tzouvelekis, L.S.; Markogiannakis, A.; Psichogiou, M.; Tassios, P.T.; Daikos, G.L. Carbapenemases in Klebsiella pneumoniae and Other Enterobacteriaceae: An Evolving Crisis of Global Dimensions. Clin. Microbiol. Rev. 2012, 25, 682–707. [Google Scholar] [CrossRef]
- Büyükcam, A.; Tuncer, Ö.; Gür, D.; Sancak, B.; Ceyhan, M.; Cengiz, A.B.; Kara, A. Clinical and microbiological characteristics of Pantoea agglomerans infection in children. J. Infect. Public Health 2018, 11, 304–309. [Google Scholar] [CrossRef]
- Markovska, R.D.; Stoeva, T.J.; Bojkova, K.D.; Mitov, I.G. Epidemiology and Molecular Characterization of Extended-Spectrum Beta-Lactamase-Producing Enterobacter spp., Pantoea agglomerans, and Serratia marcescens Isolates from a Bulgarian Hospital. Microb. Drug Resist. 2014, 20, 131–137. [Google Scholar] [CrossRef] [PubMed]
- Selmi, R.; Tayh, G.; Srairi, S.; Mamlouk, A.; Ben Chehida, F.; Lahmar, S.; Bouslama, M.; Daaloul-Jedidi, M.; Messadi, L. Prevalence, risk factors and emergence of extended-spectrum β-lactamase producing-, carbapenem- and colistin-resistant Enterobacterales isolated from wild boar (Sus scrofa) in Tunisia. Microb. Pathog. 2022, 163, 105385. [Google Scholar] [CrossRef] [PubMed]
- Puopolo, K.M.; Benitz, W.E.; Zaoutis, T.E.; Committee on Fetus and Newborn; Committee on Infectious Diseases. Management of Neonates Born at ≤34 6/7 Weeks’ Gestation With Suspected or Proven Early-Onset Bacterial Sepsis. Pediatrics 2018, 142, e20182896. [Google Scholar] [CrossRef] [PubMed]
- Puopolo, K.M. American Academy of Pediatrics (AAP) Clinical Report. New Sepsis Guidance Addresses Epidemiology, Microbiology, Recommended Empiric Treatment. Available online: https://publications.aap.org/aapnews/news/12310/New-sepsis-guidance-addresses-epidemiology (accessed on 19 November 2018).
- Singh, N.K.; Wood, J.M.; Karouia, F.; Venkateswaran, K. Succession and persistence of microbial communities and antimicrobial resistance genes associated with International Space Station environmental surfaces. Microbiome 2018, 6, 204. [Google Scholar] [CrossRef] [PubMed]
- Bortolaia, V.; Kaas, R.F.; Ruppe, E.; Roberts, M.C.; Schwarz, S.; Cattoir, V.; Philippon, A.; Allesoe, R.L.; Rebelo, A.R.; Florensa, A.R.; et al. ResFinder 4.0 for predictions of phenotypes from genotypes. J. Antimicrob. Chemother. 2020, 75, 3491–3500. [Google Scholar] [CrossRef]
- Carattoli, A.; Zankari, E.; Garcia-Fernandez, A.; Voldby Larsen, M.; Lund, O.; Villa, L.; Aarestrup, F.M.; Hasman, H. PlasmidFinder and pMLST: In silico detection and typing of plasmids. Antimicrob. Agents Chemother 2014, 58, 3895–3903. [Google Scholar] [CrossRef]
- Asai, N.; Koizumi, Y.; Yamada, A.; Sakanashi, D.; Watanabe, H.; Kato, H.; Shiota, A.; Hagihara, M.; Suematsu, H.; Yamagishi, Y.; et al. Pantoea dispersa bacteremia in an immunocompetent patient: A case report and review of the literature. J. Med Case Rep. 2019, 13, 33. [Google Scholar] [CrossRef]
- Yablon, B.R.; Dantes, R.; Tsai, V.; Lim, R.; Moulton-Meissner, H.; Arduino, M.; Jensen, B.; Patel, M.T.; Vernon, M.O.; Grant-Greene, Y.; et al. Outbreak of Pantoea agglomerans Bloodstream Infections at an Oncology Clinic—Illinois, 2012–2013. Infect. Control Hosp. Epidemiol. 2017, 38, 314–319. [Google Scholar] [CrossRef]
- Bicudo, E.L.; Macedo, V.O.; Carrara, M.A.; Castro, F.F.; Rage, R.I. Nosocomial outbreak of Pantoea agglomerans in a pediatric urgent care center. Braz. J. Infect. Dis. 2007, 11, 281–284. [Google Scholar] [CrossRef]
- Tiwari, S.; Beriha, S.S. Pantoea species causing early onset neonatal sepsis: A case report. J. Med. Case Rep. 2015, 9, 188. [Google Scholar] [CrossRef]
- Salah, A.; Al-Subol, I.; Hudna, A.; Alhaj, A.; Alqubaty, A.R.; Farie, W.; Sulieman, D.; Alnadhari, O.; Alwajeeh, T.; Alobathani, F.; et al. Neonatal sepsis in Sana’a city, Yemen: A predominance of Burkholderia cepacia. BMC Infect. Dis. 2021, 21, 1108. [Google Scholar] [CrossRef] [PubMed]
- Gaiarsa, S.; Merla, C.; Corbella, M.; Mariani, B.; Zatelli, M.; Sciabica, I.; Castelli, M.; Piazza, A.; Zecca, M.; Sassera, D.; et al. Isolation of a Colistin-Susceptible MDR Pantoea calida Harboring the mcr-9 Gene Suggests the Silent Spread of the Resistance Factor. Microb. Drug Resist. 2022, 28, 408–412. [Google Scholar] [CrossRef] [PubMed]
- Liberto, M.C.; Matera, G.; Puccio, R.; Russo, T.L.; Colosimo, E.; Focà, E. Six cases of sepsis caused by Pantoea agglomerans in a teaching hospital. New Microbiol. 2009, 32, 119–123. [Google Scholar]
- Mirtella, D.; Fedeli, P.; Scendoni, R.; Cannovo, N.; Cingolani, M. A Case of Nosocomial Outbreak of Pantoea agglomerans Related to Parenteral Nutrition Procedures. Healthcare 2021, 9, 684. [Google Scholar] [CrossRef] [PubMed]
- Izzo, I.; Lania, D.; Castro, A.; Lanzini, F.; Bella, D.; Pagani, A.; Colombini, P. Sette casi di contaminazione di CVC a permanenza (tipo “Port-a-cath”) da Pantoea agglomerans in pazienti afferenti al Servizio di Oncologia del P.O. di Iseo, Brescia [Seven cases of port-a-cath contamination caused by Pantoea agglomerans in the Oncological Service of Iseo Hospital, Brescia (Italy)]. Infez. Med. 2014, 22, 152–155. (In Italian) [Google Scholar] [PubMed]
- Arcari, G.; Di Lella, F.M.; Bibbolino, G.; Mengoni, F.; Beccaccioli, M.; Antonelli, G.; Faino, L.; Carattoli, A. A Multispecies Cluster of VIM-1 Carbapenemase-Producing Enterobacterales Linked by a Novel, Highly Conjugative, and Broad-Host-Range IncA Plasmid Forebodes the Reemergence of VIM-1. Antimicrob. Agents Chemother. 2020, 64, e02435-19. [Google Scholar] [CrossRef]

| Strain | AMC S ≤ 8 R > 8 | AMP S ≤ 8 R > 8 | P/T S ≤ 8 R > 8 | FEP S ≤ 1 R > 4 | CTX S ≤ 1 R > 1 | TAZ S ≤ 1 R > 4 | CAZ S ≤ 8 R > 8 | C/T S ≤ 2 R > 2 | CIP S ≤ 0.25 R > 0.5 | LVX S ≤ 0.5 R > 1 | ERT S ≤ 0.5 R > 0.5 | IM S ≤ 2 R > 4 | MEM S ≤ 2 R > 8 | ATM S ≤ 1 R > 4 | FOS S ≤ 32 R > 32 | COL S ≤ 2 R > 2 | AK S ≤ 8 R > 8 | CN S ≤ 2 R > 2 | SXT S ≤ 2 R > 4 |
|---|---|---|---|---|---|---|---|---|---|---|---|---|---|---|---|---|---|---|---|
| 6775PV | >64/2 (I) | >8 (R) | >32/4 (R) | >8 (R) | >8 (R) | >16 (R) | <16/4 (R) | >32/4 (R) | 0.5 (I) | ≤0.5 (S) | 1 (R) | 16 (R) | 4 (R) | ≤0.5(S) | >64 (R) | ≤0.25 (S) | ≤4 (S) | ≤1 (S) | ≤1/19 (S) |
Disclaimer/Publisher’s Note: The statements, opinions and data contained in all publications are solely those of the individual author(s) and contributor(s) and not of MDPI and/or the editor(s). MDPI and/or the editor(s) disclaim responsibility for any injury to people or property resulting from any ideas, methods, instructions or products referred to in the content. |
© 2023 by the authors. Licensee MDPI, Basel, Switzerland. This article is an open access article distributed under the terms and conditions of the Creative Commons Attribution (CC BY) license (https://creativecommons.org/licenses/by/4.0/).
Share and Cite
Merla, C.; Mileto, I.; Gaiarsa, S.; Achille, C.; Ghirardello, S.; Corbella, M.; Baldanti, F.; Cambieri, P. Surveillance in a Neonatal Intensive Care Unit Allowed the Isolation of a Strain of VIM-Producing Pantoea brenneri. Antibiotics 2023, 12, 98. https://doi.org/10.3390/antibiotics12010098
Merla C, Mileto I, Gaiarsa S, Achille C, Ghirardello S, Corbella M, Baldanti F, Cambieri P. Surveillance in a Neonatal Intensive Care Unit Allowed the Isolation of a Strain of VIM-Producing Pantoea brenneri. Antibiotics. 2023; 12(1):98. https://doi.org/10.3390/antibiotics12010098
Chicago/Turabian StyleMerla, Cristina, Irene Mileto, Stefano Gaiarsa, Cristian Achille, Stefano Ghirardello, Marta Corbella, Fausto Baldanti, and Patrizia Cambieri. 2023. "Surveillance in a Neonatal Intensive Care Unit Allowed the Isolation of a Strain of VIM-Producing Pantoea brenneri" Antibiotics 12, no. 1: 98. https://doi.org/10.3390/antibiotics12010098
APA StyleMerla, C., Mileto, I., Gaiarsa, S., Achille, C., Ghirardello, S., Corbella, M., Baldanti, F., & Cambieri, P. (2023). Surveillance in a Neonatal Intensive Care Unit Allowed the Isolation of a Strain of VIM-Producing Pantoea brenneri. Antibiotics, 12(1), 98. https://doi.org/10.3390/antibiotics12010098

